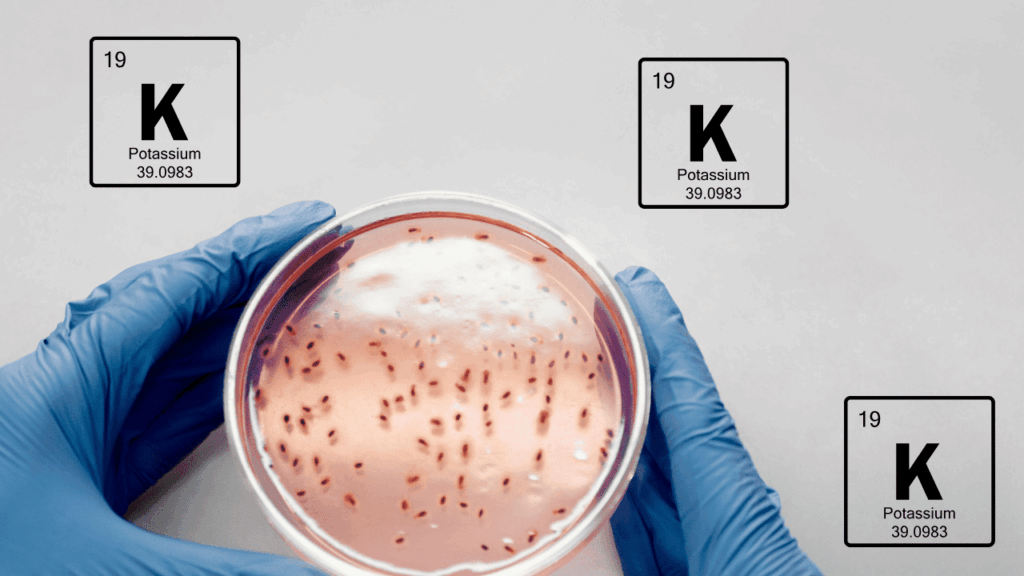

Os microrganismos solubilizadores de Potássio, são aqueles responsáveis por solubilizar minerais que de alguma forma estão indisponíveis para as plantas, e torna-los disponíveis. Podemos dizer que os mecanismos de ação desses agentes são bem parecidos com aqueles solubilizadores de fósforo. Neste artigo, vamos discutir a impotância geral deste macronutriente, os principais microrganismos associados, e brevemente pontuar os principais modos de ação e seus resultados.
Importância do Potássio para as Plantas
O potássio é um nutriente ativador de mais de 60 enzimas e atua no controle da atividade enzimática em inúmeros processos, tanto fisiológicos como metabólicos das plantas.
Entre estes processos, podemos citar:
– Fotossíntese
– Síntese de Proteínas
– Síntese de Carboidratos
– Regulação Estomática
– Tolerância a Seca
– Processos de Transporte nos Tecidos Vasculares
– Crescimento Geral das Plantas
Principais Gêneros e Espécies
- Bactérias:
Dentre os principais grupos de bactérias solubilizadoras de potássio (BSK) já foram descritas as
espécies Acidothiobacillus ferrooxidans, Paenibacillus spp., P. mucilaginosus, P. frequentans, P. glucanolyticus, Bacillus mucilaginosus, B. edaphicus, B. circulans, Arthrobacter sp., Enterobacter
hormaechei, Cladosporium sp., Aminobacter sp., Sphingomonas sp. e Burkholderia sp
- Fungos:
Entre os fungos, destacam-se os gêneros Aspergillus, Penicilliumi, Cladosporium e os fungos micorrízicos do gênero Glomus.
Mecanismos de Ação
As duas figuras a seguir mostram os diferentes mecanismos de ação utilizados por fungos e bactérias.


Principais Resultados com Bactérias Solubilizadoras de Potássio
Singh et al. (2010):
- Bacillus mucilaginosus mostrou maior capacidade de mobilizar K (a partir de mica) em trigo e milho, aumentando biomassa, conteúdo de K, proteína e clorofila.
Ashfaq et al. (2020):
- 42 estirpes isoladas de solos salinos (arroz); 5 selecionadas (Acinetobacter pittii, Rhizobium pusense, Cupriavidus oxalaticus, Ochrobactrum ciceri) melhoraram crescimento, peso seco/fresco e clorofila sob estresse salino.
Khani et al. (2019):
- Enterobacter cloacae aumentou produção de grãos de trigo, correlacionada ao maior K em grãos, parte aérea e raízes; solo com mais K trocável e solúvel.
Badr et al. (2006):
- BSK + minerais ricos em K/P → aumento de massa seca e absorção de nutrientes em sorgo.
Ali et al. (2021):
- Bacillus cereus + feldspato em batata → maior altura, peso seco, absorção de N, P, K e maior produção de tubérculos.
Principais Resultados com Fungos Solubilizadores de Potássio
Biswas (2011):
- Aspergillus awamori em composto com mica + fosfato → maior produção de soja e batata, mais N, P e K no solo e nas plantas.
Maity et al. (2019):
- Penicillium pinophilum em romã → +35% de produção, melhor qualidade do fruto (peso, suco, açúcar, ácido ascórbico, fenóis) e mais P e K nas folhas e frutos.
Prajapati et al. (2013):
- Enterobacter hormaechei e Aspergillus terreus + feldspato → maior crescimento e mobilização de K em quiabo.
Mohamed et al. (2017):
- Leveduras Pichia anomala e Rhodotorula glutinis → alta solubilização de mica; maior crescimento e absorção de K em milho, especialmente sob baixa adubação (50% da dose).
Literatura Consultada:
